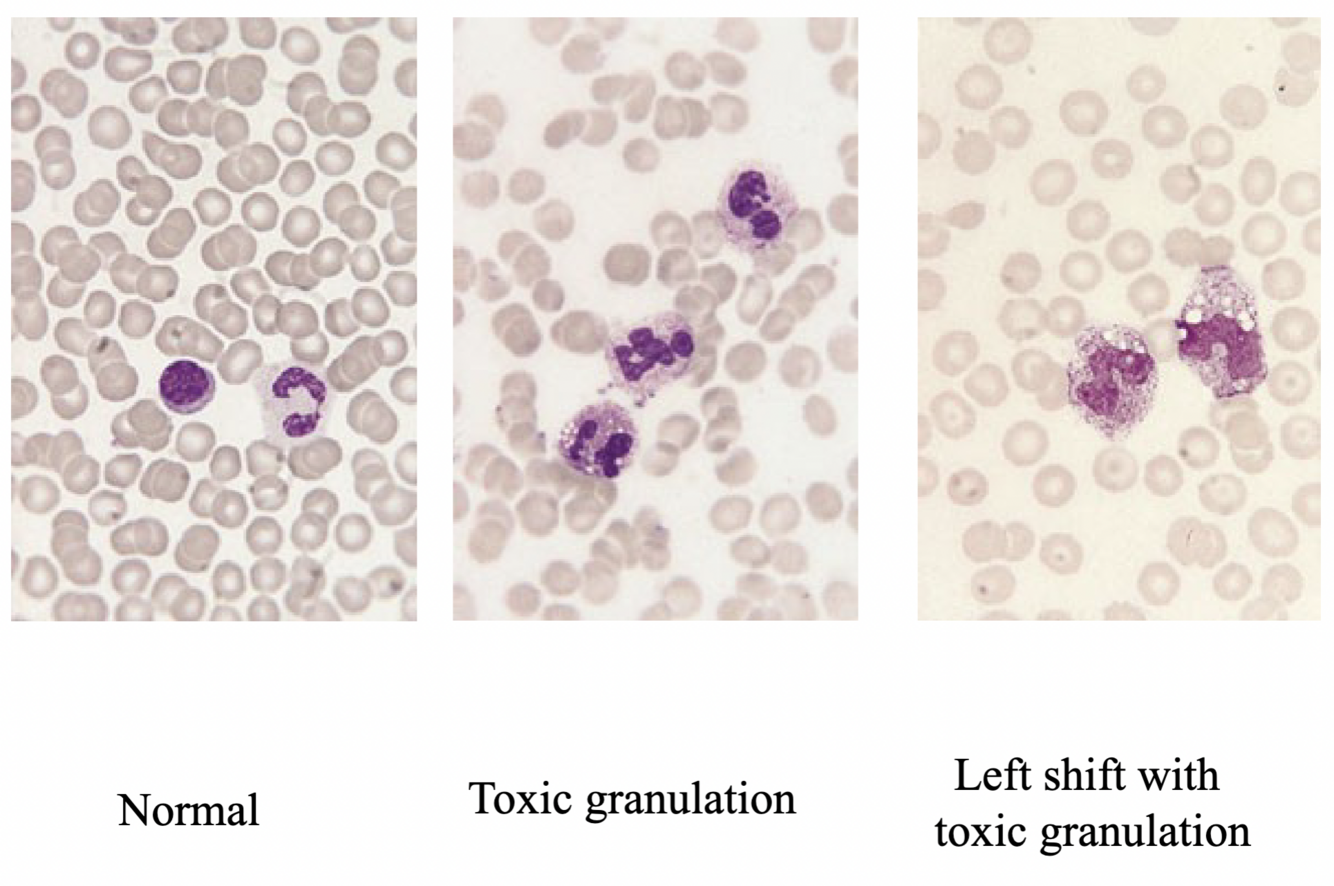
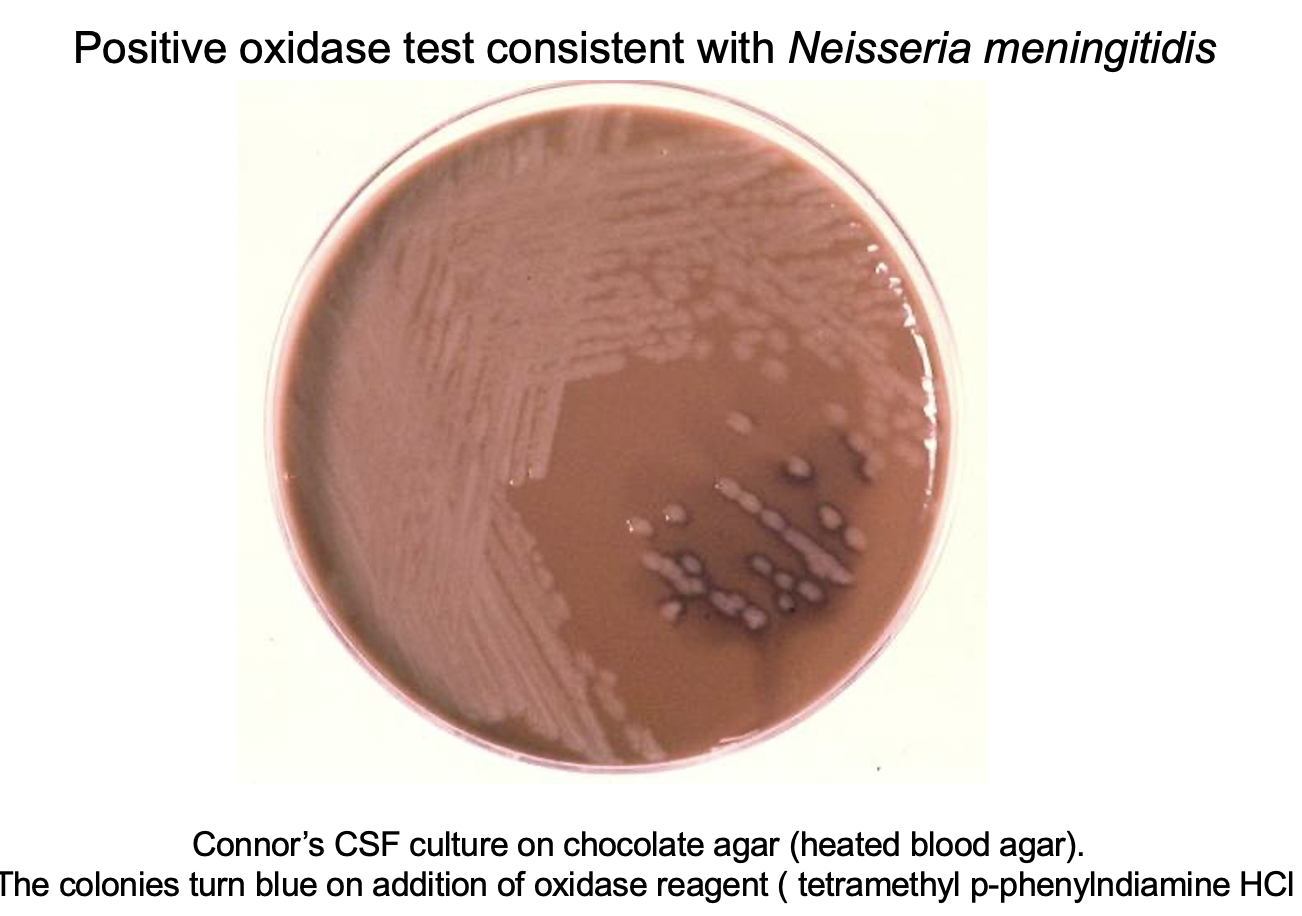

Meningitis= infection of the protective membranes (meninges).
Can cause meningococcal sepsis (septicaemia) and result in permanent brain/nerve damage.
What are the symptoms of meningitis? Relate the symptoms w the pathological sign
Fever, cold extremities, clammy, tachycardia and resp distress (signs of septic shock)
Mixed rash with petechiae (signs of meningococcal disease)
Neck retraction and an arched back (signs of meningeal inflammation)
Refusal to feed, photosensitivity
Blood screen shows left shift w toxic neutrophil granulation
Toxic neutrophil granulation inc cytoplasmic vacuoles, granulation, Dohle bodies
What is Brudzinski’s sign?
A physically demonstrable symptom of meningitis= Brudzinski’s sign.
Severe neck stiffness causes a patient’s hips and knees to flex when the neck is flexed

What is the first line of action when a patient is administered to hospital with suspected meningitis?
O2 to improve hypoxaemia.
Give fluids. Investigations + blood samples.
Fluid resuscitation using normal saline (20ml/kg).
A dose of ceftriaxone- broad spectrum, only 1-2 times a day.
Patient is intubated and ventilated.
Lumbar puncture to obtain csf sample, only if pt is fairly stable
What are the investigations for suspected meningitis?
Microbiology, Biochemistry, Haematology
Microbiology tests: blood culture, meningococcal PCR, throat swab- useful bc most likely source to find meningitis bacterium
Biochemistry: electrolytes, blood gas as a way to monitor Pa02 etc
Haematology: FBC, clotting screen to check for sepsis
What are the types of rashes?
Haemorrhagic is non blanching

What are the mechanisms for red rash on the skin?

What is another type of rash that can be mistaken for a meningoccocal infection?
Others inc Thoracic Zoster – reactivation of VZV along the T4 dermatome
Chickenpox

CSF parameters investigated for suspected meningitis

Draw a table to describe the properties of bacteria causing meningitis

What would a positive test culture for N meningitis look like?
Describe molecular and antigen detection tests
PCR: detects bacteria specific DNA. V sensitive but complex, takes time
Latex agglutination test: less sensitive, rapid. Detects:
Strep B and strep pneumonia, HiB, E.coli K1
N meningitidis types A,B,C,Y and W
N.meningitidis -100% killed in first 4 hours post antibiotics, so we need Ag detection systems
How can we serotype bacteria using latex agglutination?
What is it useful for?
Bacteria can be “serotyped” either directly from CSF sample, or from an isolated colony from a culture plate.
The bacteria are mixed w specific Abs; agglutination indicates the Serotype
Useful for public health, finds infection type/source, helps w vaccine planning etc

In a case of suspected meningitis/septicaemia :
What should be the first healthcare action in a primary setting, ie GP?
Injection of penicillin, i/m or i/v- unless pt has severe penicillin allergy
If allergic, use injectable cephalosporin (or chloramphenicol)
What is the first line antibiotic treatment in hospital with a case of meningitis?

Define a cluster or outbreak and relate this to meningitis
2 confirmed cases with the same serogroup (e.g. N.meningitidis group B), w/in a defined group (e.g. school, work place), arising within 4 weeks
Meningitis is LEGALLY NOTIFIABLE, and is spread between close contacts
Meningococcus esp can cause outbreaks
A close contact of a meningitis patient is offered chemoprophylaxis and vaccination. Which antibiotics are used?
1 dose of Ciprofloxacin
Or 2 doses of Rifampicin for 2 days- this is used less bc it can decrease half life of other medications
Penicillin does not remove meningitis carriage from naso-pharynx, so its not used
Describe the Etiology of ‘Aseptic’ Meningitis
meningitis experts argue that health and vitality heals (helps remember this)

for bacterial meningitis, the causative agent varies with age. Explain these differences



